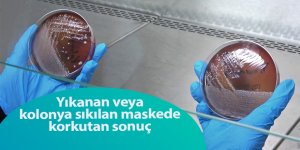
Yıkanan veya kolonya sıkılan maskede korkutan sonuç - samsun haber

- Başkan İhsan Kurnaz: ‘İLKEM hayalleri gerçeğe dönüştürüyor’
- Canik'in Genç Zanaatkârları Gönüllere Dokunuyor
- BÜYÜKŞEHİR’DEN SULAMA TESİSLERİ PROJESİ İLE TARIMA DESTEK
- BAŞKAN DOĞAN’DAN İLÇELERE PARK MÜJDESİ
- Başkan İhsan Kurnaz: ‘Esnafımızın Kapısını Çalıyor, Gönüllere Dokunuyoruz’
- Başkan İhsan Kurnaz: ‘Gençlerimiz Geleceğe En Değerli Hazinemiz’
- SAMSUN’DA HARİFİYATTA DİJİTAL DÖNÜŞÜM ADIM ADIM GERÇEKLEŞTİRİLİYOR
- Samsun’da Avrupa Miras Günleri başladı
- Başkan İhsan Kurnaz: ‘İlkadım'ın Gücü Saha Personellerinde’
- Atakum Belediyesinin 29 Ekim programı kentte unutulmaz anlar yaşattı